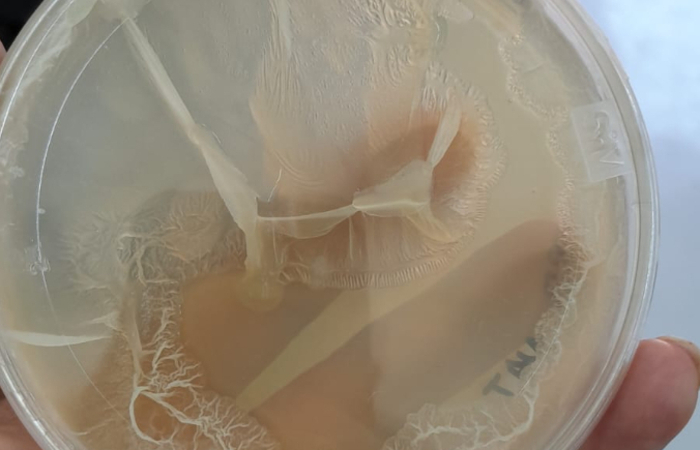

El desarrollo de la planta piloto de la Biorrefinería IBERO sigue avanzando, ya que el equipo a su cargo acaba de adquirir un filtro prensa que separa los líquidos de los sólidos en el proceso que realiza para obtener etanol, ácido láctico, edulcorantes, alginatos, aromas y polímeros, usados en las industrias farmacéutica, alimentaria, de limpieza y dental.
La Mtra. Lorena Leticia Pedraza Segura, Académica del Departamento de Ingeniería Química, Industrial y de Alimentos de la Universidad Iberoamericana Ciudad de México, explicó que esta planta piloto reutiliza el olote de maíz y el sargazo para la elaboración de estos compuestos químicos.

“Una biorrefinería usa materia prima orgánica como residuos agrícolas o marinos y se les da un uso. Se le llama valorización de la biomasa (…) Al sargazo se le puede dar un uso y hay manera de darle salida como combustible creando productos químicos de valor”, explicó.
De la planta piloto de la Biorrefinería IBERO, abundó, se pueden obtener datos experimentales y sustentables con la asistencia de especialistas, quienes efectúan modelos matemáticos que predicen condiciones para el escalamiento a volúmenes mayores de estos productos.
Recordó que el proyecto de la planta piloto de la biorrefinería IBERO (ubicada en el Anexo del Edificio F) comenzó a nivel laboratorio a partir de un proyecto del Consejo Nacional de Humanidades, Ciencias y Tecnologías (Conahcyt) para abatir los cientos de toneladas de desechos orgánicos de la Central de Abastos, convirtiéndolos en distintos tipos de combustible.

La Académica contó que posteriormente lograron financiamientos del Fomento de Investigación y Cultura Superior A.C. (FICSAC), Patronato de la IBERO, y del Instituto de Investigación Aplicada y Tecnología (InIAT), con los cuales se compró equipo para este proyecto.
“El proyecto estaba enfocado en obtener alcohol y nos dimos cuenta de que podíamos obtener más, como aromas y enzimas. Empezamos a hacer una colección de microorganismos que son propios de los residuos ”, manifestó.
¿Cómo funciona la planta piloto de la Biorrefinería IBERO?
Las biorrefinerías son beneficiosas para el medio ambiente, ya que evitan la dispersión de residuos orgánicos o la quema de residuos agrícolas, las cuales son prácticas muy extendidas en el país que generan emisiones tóxicas cuando están combinadas con plásticos o recipientes con pesticidas. La Mtra. Pedraza Segura contó cómo funciona la planta piloto de la Biorrefinería IBERO.

“Llega la materia prima, se tiene que moler y reducir el tamaño de partícula, se somete a un tratamiento químico y biológico, de ahí se obtienen los azúcares que los microorganismos pueden usar", acotó.
Sobre los microorganismos, que descomponen los residuos, precisó que la IBERO tiene un convenio con el Centro de Investigación y Asistencia en Tecnología y Diseño del Estado de Jalisco (Ciatej), el cual ayuda a identificarlos, lo cual es importante para saber con qué se está trabajando.
| La Mtra. Lorena Pedraza muestra uno de los microorganismos de colección. Foto: Cortesía Lorena Pedraza |
“Hay colaboración con varias universidades. (En la IBERO) tenemos todo integrado, la parte del tratamiento de la biomasa. No es tomar el residuo y ya ponerlo a que se obtenga algo de él, sino hay que darle un procesamiento”, apuntó.
La especialista especificó que la planta piloto de la Biorrefinería IBERO se sustenta en procesos biotecnológicos y en tener sus propios microorganismos relacionados con la biomasa y que se pueden adaptar mejor a esos residuos, ya sea para obtener alcohol, proteínas o polímeros.
“En la IBERO estamos dentro del marco de un proceso que pueda economizar el agua, de los compuestos químicos que se usan para los procedimientos iniciales del tratamiento de la biomasa. Respetar que no salga más caro en términos de sustentabilidad”, puntualizó.
Texto y Fotos: Luis Reyes
Notas relacionadas:
